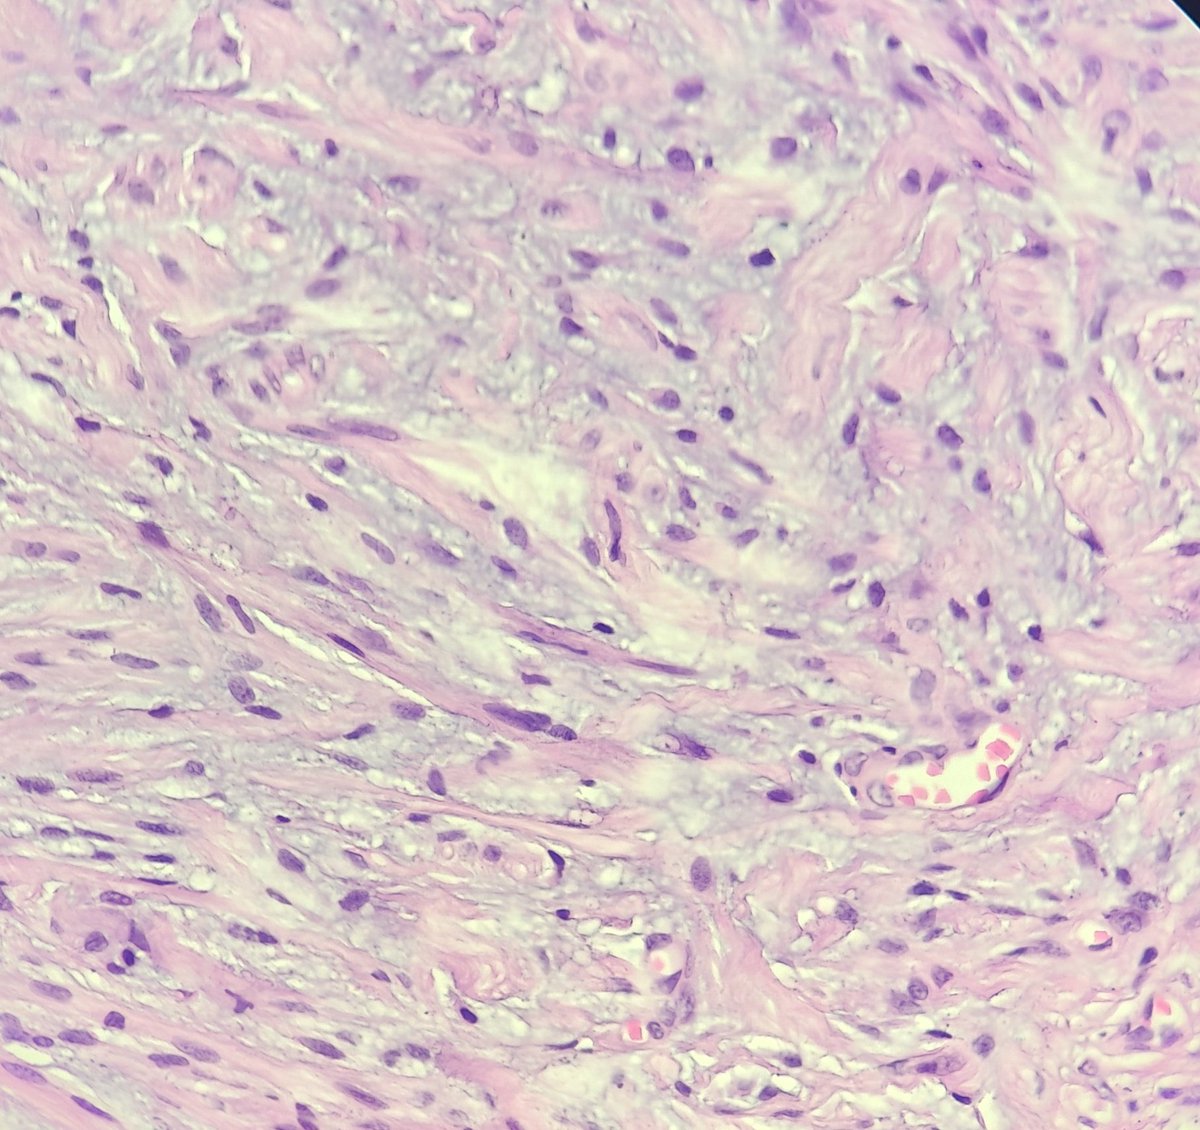
Vasant panchami special 🌸🌼
Elderly male scalp lump

#pathtwitter #headandneckpath #dermpath

Kala Suresh
@kspatho
Consultant Pathologist, Dr KMH
ID: 767055061847412736
20-08-2016 17:45:52
443 Tweet
204 Takipçi
1,1K Takip Edilen



6.1 cm renal mass. Diagnosis? Gross photo in the chat. #PathTwitter Mass General Brigham Pathology MGH Pathology


30/M FNAC Sternal lesion #cytopath ##pathtwitter #pathresidents Pepe Jiménez Heffernan Vidya Monappa Olaleke Folaranmi Kalyani Bambal